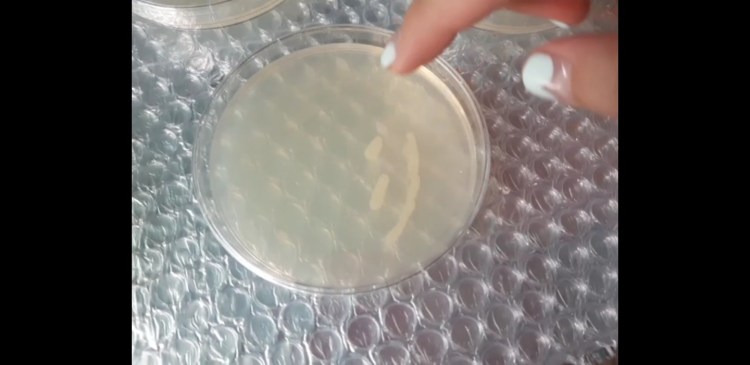
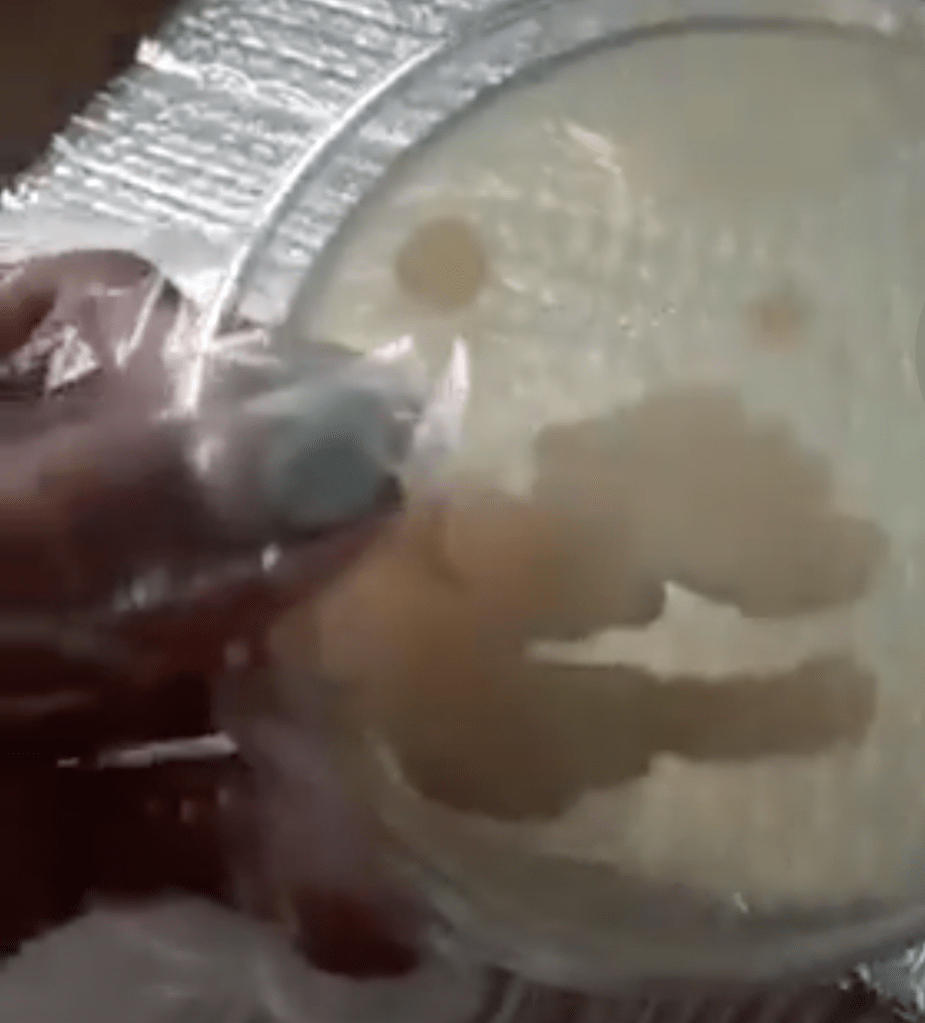
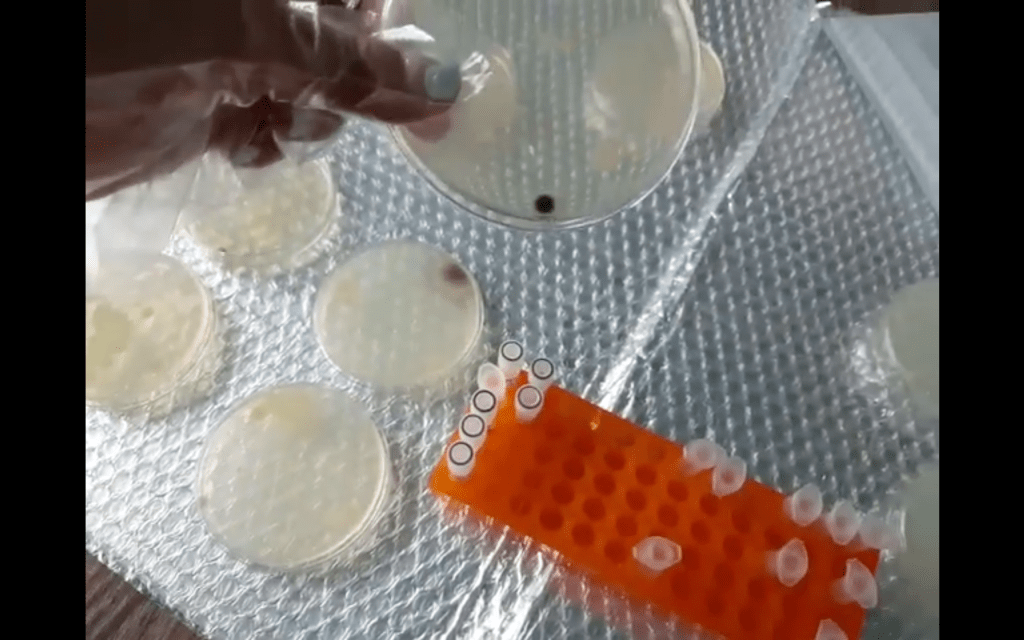

The results I had expected after 24 hours did not seem to show very evidently.
원래 기대했던 결과가 생각보다 많이 안 나타나서(?) 좀 실망했어요.
Interestingly, there were black circles on both the LB Agar and LB Strep/Kan/Arabinose Agar plates. I think they are probably mold, because according to my research, the black mold possessed similar external traits to those of a Aspergillus mold and also those of an Alternaria mold.
그래도, 신기한 생명체가 자라기 시작했어요. LB Agar랑 LB Strep/Kan/Arabinose Agar 페트리 접시에 검은 원? 이 생겼어요. 정확히 그 원의 정체가 뭐인지는 잘 모르겠지만, 인터넷에 찾아본 결과에 추측하자면, 아마도 곰팡이인 것 같아요. 인터넷에 찾아볼때, 아스페르길루스 곰팡이랑 알테나리아 곰팡이의 외부특성??이 많이 비슷해서 아마도 그 두 곰팡이 중에 한 종류이거나 아니면 아예 다른 종일 수도 있어요..
The bacteria in the LB Agar plates grew a LOT, especially the bacteria I had scraped off for making the bacterial transformation mix. While scraping it, I guess the already-contamined loop I used to scrape the bacteria off touched the uncontaminated areas, spreading the bacteria.
실험 맨 처음에 LB Agar접시에 키운 박테리아가 엄청! 많이 자랐어요. 특히, bacterial tranformation mix 액체 만들려고 긁었던 페트리 접시에 들어있던 박테리아가 엄청 많이 자랐어요! 아마도 멸균루프로 긁으면서 루프에 묻어있는 박테리아가 오염되지 않은 부분에 묻으면서 자란 것 같아요.

There were also, a few orange specks on the LB Agar plates, and also this dried up, volcano-shaped mold..
그리고, 작은 주황색 동그라미 모양의 곰팡이도 자라기 시작했어요. 화산처럼 생긴 작은 곰팡이도 자랐고요.
For the LB Strep/Kan/Arabinose agar, all the plates had all kinds of various molds growing on the agar. I honestly am so confused why this result came out like this…
모든 LB Strep/Kan/Arabinose agar접시들이 다 특이하고 다양한 곰팡이들이 자랐어요. 도대체 결과가 왜 이렇게 나왔는지가 참 의문이지만요..
